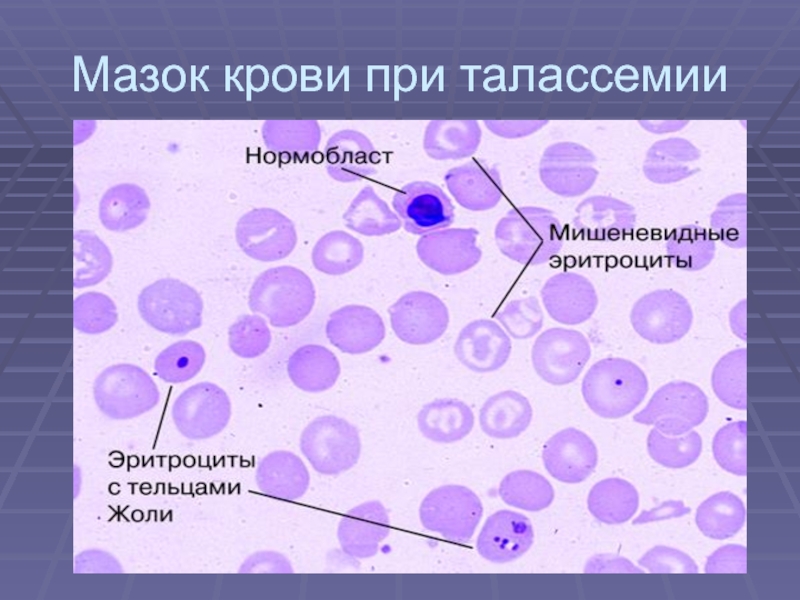

Разделы презентаций
- Разное
- Английский язык
- Астрономия
- Алгебра
- Биология
- География
- Геометрия
- Детские презентации
- Информатика
- История
- Литература
- Математика
- Медицина
- Менеджмент
- Музыка
- МХК
- Немецкий язык
- ОБЖ
- Обществознание
- Окружающий мир
- Педагогика
- Русский язык
- Технология
- Физика
- Философия
- Химия
- Шаблоны, картинки для презентаций
- Экология
- Экономика
- Юриспруденция
Гемолитические анемии
Содержание
- 1. Гемолитические анемии
- 2. Гемолитические анемии- Это группа заболеваний, различающихся по
- 3. Гемолитичекие анемииАНЕМИИ ОБУСЛОВЛЕННЫЕ УКОРОЧЕНИЕМ ДЛИТЕЛЬНОСТИ ЖИЗНИ ЭРИТРОЦИТОВ
- 4. Виды гемолиза:Внутриклеточный (секвестрационный)-происходит в клетках ретикуло-эндотелиальной системы,
- 5. Классификация ГАВРОЖДЕННЫЕЭРИТЦИТОПАТИИ =мембранопатии (МИКРОСФЕРОЦИТОЗ-б-нь Минковского-Шоффара; СФЕРОЦИТОЗ; ОВАЛОЦИТОЗ;
- 6. Общие признаки гемолизаЖелтухаСпленомегалияКризовое течение.Снижение уровня гемоглобинаРетикулоцитозГипербилирубенемия (непрямая фракция)УробилинурияГиперплазия эритроидного росткаПоложительная реакция Кумбса в разв.>1:4Î ферритина
- 7. Кризы 2 типов - гемолитический и апластический
- 8. Наследственная микросфероцитарная гемолитическая анемия (б-нь Минковского-Шоффара) -
- 9. Этиологиянаследуется по аутосомно-доминантному типу, встречается в основном гетерозиготная форма заболевания.
- 10. Патогенез
- 11. Клиническая картина.1. Внешний вид – монголоидное лицо,
- 12. Слайд 12
- 13. Гематологически-умеренная анемия, Rtc>10%, сфероциты, средняя концентрация Hb
- 14. Дефицит Г-6-ФДНаследование сцеплено с Х-хромосомой.Чаще проявляется у
- 15. Варианты ДГ-6-ФДГ4 класса (ВОЗ)1-й класс — варианты с
- 16. 3-й класс — варианты с уровнем активности фермента
- 17. КлиникаПровоц. ф-рТемная мочаЧернаямочаОПНЛихорадкарвотапоносгипотонияСплено-гепато-мегалия
- 18. ДиагностикаАнемия;Ретикулоцитоз;Лейкоцитоз (иногда, особенно у детей, количество лейкоцитов
- 19. Лечениенеобходимо лишь при выраженных признаках острого разрушения
- 20. Талассемия - гетерогенная группа гемоглобинопатий, в основе
- 21. Патогенезмутация в локусе ß-глобина на 11-й паре
- 22. При ß-талассемии накапливается также HbF, обладающий большим
- 23. α,β,γ,δ-талассемияКлиника – большая голова, запавший нос, монголоидные
- 24. Мазок крови при талассемии
- 25. Большая талассемия: внешний вид. Гепатосплено-мегалия и низкорослость.
- 26. Большая талассемия: спленомегалия
- 27. Серповидно-клеточная анемияКлиника- башенный череп, инфантилизм, тромбозы сосудов
- 28. Мазок крови при серповидноклеточной анемии
- 29. Приобретенные гемолитические анемииГемолитическая болезнь плода - антигенные
- 30. Аутоиммунные гемолитические анемии Симптоматические – гемобластозы, СКВ,
- 31. Патогенез АИГАНеполные тепловые агглютинины фиксируются на эритроцитах,
- 32. Тепловые гемолизины, холодовые агглютинины и двухфазные гемолизины
- 33. ГА с тепловыми гемолизинамиКлиника- постепенное начало, умеренная
- 34. Аутоиммунная гемолитическая анемия: желтушность склер.
- 35. Слайд 35
- 36. ГА с неполными тепловыми агглютининамиКлиника- м.б., внезапное
- 37. ГА с полными холодовыми агглютининами.Клиника-начало постепенное, слабость,
- 38. Слайд 38
- 39. Лечение ГАУстранение причины острого гемолиза;При кризах –
- 40. Апластическая анемия- это функциональная недостаточность костного мозга, в результате чего нарушается пролиферация и дифференциация клеток последнего.
- 41. Этиология .Ионизирующая радиация;Химические вещества;Цитотоксические препараты;Вирусные инфекции (вирусный
- 42. Классификация1. Наследственные (врожденные);2. Приобретенные: - первичные (идиопатические); - вторичные.
- 43. Клиника1.Анемический синдром -слабость, одышка, сердцебиение при физической
- 44. 3.С-м инфекционных осложнений –пневмонии, ангины, отиты, пиелиты, абсцессы);4.Гематологический синдром – характерные изменения в крови.
- 45. Течение:По тяжести течения:Нетяжелая (L
- 46. Диагностика:ОАК – анемия разной степени выраженности;Панцитопения (лейкопения, нейтро-пения с абсолютной лимфопенией; тромбоцитопения);Анизо-пойкилоцитоз;Нормо-или-макроцитоз;Ускоренная СОЭ.
- 47. Диагностика:Миелограмма - опустошенный костный мозг, местами имеются
- 48. Апластическая анемия: кровоизлияния в слизистые.
- 49. ЛЕЧЕНИЕ-Антилимфоцитарный глобулин (АТГАМ), -циклоспорин, ГК, -эритропоэтин (эпрекс,
- 50. БЛАГОДАРЮ ЗА ВНИМАНИЕ
- 51. Скачать презентанцию
Гемолитические анемии- Это группа заболеваний, различающихся по этиологии , патогенезу, клинической картине и методам лечения, но объединенных одним основным признаком- укорочением продолжительности жизни эритроцитов и усиленным их разрушением, что и приводит
Слайды и текст этой презентации
Слайд 3Гемолитичекие анемии
АНЕМИИ ОБУСЛОВЛЕННЫЕ УКОРОЧЕНИЕМ ДЛИТЕЛЬНОСТИ ЖИЗНИ ЭРИТРОЦИТОВ В СИЛУ ИХ
ВНУТРЕННЕГО ДЕФЕКТА ИЛИ ВНЕШНИХ НЕБЛАГОПРИЯТНЫХ ФАКТОРОВ
ЭПИДЕМИОЛОГИЯ: у
0,5 - 1,0% населения (в Средиземноморье, Африке, на Кавказе - 5 - 50% населения).Слайд 4Виды гемолиза:
Внутриклеточный (секвестрационный)-происходит в клетках ретикуло-эндотелиальной системы, т.е.в селезенке, сопровождается
увеличением свободного билирубина, уробилина в моче, кале и образованием конкрементов
в ж\п и желчных протоках.Внутрисосудистый гемолиз-гемоглобин проникает в плазму и выделяется с мочой либо в неизмененном виде, либо в виде гемосидерина.
Слайд 5Классификация ГА
ВРОЖДЕННЫЕ
ЭРИТЦИТОПАТИИ =мембранопатии (МИКРОСФЕРОЦИТОЗ-б-нь Минковского-Шоффара; СФЕРОЦИТОЗ; ОВАЛОЦИТОЗ; СТОМАТОЦИТОЗ)
ГЕМОГЛОБИНОПАТИИ (ТАЛАССЕМИЯ, СЕРПОВИДНОКЛЕТОЧНАЯ
АНЕМИЯ)
ФЕРМЕНТОПАТИИ (ДЕФИЦИТ Г-6-ФДГ, ГЕКСОКИНАЗЫ, ПИРУВАТКИНАЗЫ, ГЕКСОФОСФАТИЗОМЕРАЗА –нарушение выработки АТФ
II.
ПРИОБРЕТЕННЫЕОСТРЫЕ (МАРШЕВАЯ Hb –УРИЯ, ПОСТТРАНСФУЗИОННЫЕ, ТОКСИЧЕСКИЕ)
ХРОНИЧЕСКИЕ (Б-НЬ МАРКИАФАВЫ-МИКЕЛЕ,ИММУННЫЕ ГА, СИМПТОМАТИЧЕСКИЕ ГА)
Слайд 6Общие признаки гемолиза
Желтуха
Спленомегалия
Кризовое течение.
Снижение уровня гемоглобина
Ретикулоцитоз
Гипербилирубенемия (непрямая фракция)
Уробилинурия
Гиперплазия эритроидного ростка
Положительная
реакция Кумбса в разв.>1:4
Î ферритина
Слайд 7Кризы 2 типов - гемолитический и апластический (реже).
Гемолитический-при стрессе, охлаждении,
беременности. Желтуха, но желчных пигментов в моче нет. М.б.боли в
животе, рвота, лихорадка.Апластический- при вирусных инфекциях. Аплазия костного мозга.
Слайд 8Наследственная микросфероцитарная гемолитическая анемия (б-нь Минковского-Шоффара) -
Дефект белков мембраны
эритроцитов, приобретающих сферическую форму с последующим их разрушением макрофагами селезенки.
Широко распространена в Европе, в меньшей степени — на Африканском континенте, в Японии и других странах, нередко встречается в нашей стране. Она проявляется в любом возрасте, чаще в детском и подростковом, встречается у близких родственников больного. Существует бессимптомное носительство гена микросфероцитоза.
Слайд 9Этиология
наследуется по аутосомно-доминантному типу, встречается в основном гетерозиготная форма заболевания.
Слайд 11Клиническая картина.
1. Внешний вид – монголоидное лицо, «башенный» череп, микрофтальм,
высокое небо и т.п.;
2. Слабость, быстрая утомляемость, одышка при
нагрузке, сердцебиение, головокружение. 3. Бледность кожи и слизистых, желтушность склер, ЖКБ-у 85%. М.б. трофические язвы голеней.
Слайд 13Гематологически-умеренная анемия, Rtc>10%, сфероциты, средняя концентрация Hb повышена до 37-39%.
(особенно при инкубации при 37º С). Продолжительность жизни эритроцитов снижена.
Терапия
- Спленэктомия. Слайд 14Дефицит Г-6-ФД
Наследование сцеплено с Х-хромосомой.
Чаще проявляется у мужчин.
Факторы риска:
-инфекции и
другие остро развивщиеся заболевания (н-р, диабетический кетоацидоз);
-лекарственные препараты: СА, противомалярийные,
нитрофураны, анальгетики, аспирин, противо-гельминтные препараты;-продукты питания (конские бобы, черника, голубика)
Слайд 15Варианты ДГ-6-ФДГ
4 класса (ВОЗ)
1-й класс — варианты с хронической гемолитической анемией.
2-й класс
— варианты с уровнем активности фермента в эритроцитах 0—10% от
нормы, носительство которых обусловливает отсутствие гемолитической анемии вне обострения, а обострения связаны с приемом лекарств или употреблением в пищу конских бобов.Слайд 163-й класс — варианты с уровнем активности фермента в эритроцитах 10—60%
от нормы, при которых могут быть легкие признаки гемолитической анемии,
связанные с приемом лекарств.4-й класс — варианты с нормальным или близким к норме уровнем активности фермента без каких-либо проявлений.
Слайд 18Диагностика
Анемия;
Ретикулоцитоз;
Лейкоцитоз (иногда, особенно у детей, количество лейкоцитов может стать очень
большим (100 х 109/л и выше).
Свободный Hb;
Гипербилирубинемия.
В моче
также появляется гемоглобин.Слайд 19Лечение
необходимо лишь при выраженных признаках острого разрушения эритроцитов. При гемолитической
анемии 1-го класса иногда спленэктомия.
При нетяжелых гемолитических кризах с
устранение причинного фактора. Слайд 20Талассемия -
гетерогенная группа гемоглобинопатий, в основе которых лежит снижение
синтеза полипептидных цепей, входящих в структуру нормального гемоглобина А.
Талассемия
- это мишеневидно-клеточная анемия с нарушенным соотношением НЬА и HbF, при этом возможна частичная недостаточность определенной цепи или ее полное отсутствие при преобладании другой цепи.Слайд 21Патогенез
мутация в локусе ß-глобина на 11-й паре хромосом нарушает синтез
ß-глобиновой цепи. Вследствие неадекватного синтеза гемоглобина развивается гипохромная анемия. Преципитаты
избыточного количества а-цепей удаляются из эритроцитов и эритрокариоцитов клетками ретикулогистиоцитарной системы; при этом клетки повреждаются и быстрее разрушаются.Слайд 22При ß-талассемии накапливается также HbF, обладающий большим сродством к кислороду;
однако отдача его тканям затруднена, что приводит к их гипоксии.
Неэффективный эритропоэз способствует расширению плацдарма кроветворения, что отражается на структуре скелета; вместе с тем деструкция эритрокариоцитов в костном мозге ведет к повышенному всасыванию железа и патологической перегрузке организма железом.Слайд 23α,β,γ,δ-талассемия
Клиника – большая голова, запавший нос, монголоидные черты лица, желтушность,
бледность, гепато-спленомегалия, хронические язвы голеней, отеки до анасарки. Часто инфекции,
которые являются причина-ми смерти.Rg-утолщение губчатого слоя свода черепа.
Гематологическая картина- гипохромная анемия, при повышенном содержании Fe, микроцитоз, СОЭ..
Слайд 27Серповидно-клеточная анемия
Клиника- башенный череп, инфантилизм, тромбозы сосудов ведут к поражению
суставов, м.б., асептический некроз головок костей, часты сосудистые нарушения зрения,
повторные инфаркты селезенки.Гематологическая картина - нормохромная анемия, эритроциты серповидной формы, ретикулоцитоз, СОЭ в норме.
Слайд 29Приобретенные гемолитические анемии
Гемолитическая болезнь плода - антигенные различия Er матери
и плода, а/т матери проникают через плаценту и разрушают Er
плода (антигены системы резус D,реже а/г С,Е и групповых а/г А и В.Клиника- гепатоспленомегалия, желтуха в 1-е сутки, кардиомегалия и НК, увеличение непрямого билирубина поражение н.с. (судороги, гипертонус, нистагм).
Гематологически - анемия, ретикулоцитоз, лейкоцитоз со сдвигом влево.
Лечение- симптоматическое.
Слайд 30Аутоиммунные гемолитические анемии
Симптоматические – гемобластозы, СКВ, РА, NeO, иммунодефицитные
состояния.
Идиопатические:
-с неполными тепловыми агглютининами;
-с тепловыми гемолизинами;
-с
полными холодовыми агглютининами;-с двухфазными гемолизинами.
Слайд 31Патогенез АИГА
Неполные тепловые агглютинины фиксируются на эритроцитах, не вызывая их
агглютинации, изменяя проницаемость мембраны эритроцитов для ионов натрия, развивается сфероцитоз,
который приводит к элиминации эритроцитов в селезенке – гемолиз внутриклеточный.Слайд 32
Тепловые гемолизины, холодовые агглютинины и двухфазные гемолизины вызывают разрушение эритроцитов
в сосудистом русле, тем самым приводят к развитию сосудистого гемолиза.
Слайд 33ГА с тепловыми гемолизинами
Клиника- постепенное начало, умеренная желтуха. Селезенка и
печень увеличена менее чем у ½. Характерно – черная моча.
М.б. тромбозы вен боли в животе.Анализ крови - анемия, ретикулоцитоз, лейкоцитоз со сдвигом влево.
Анализ мочи – протеинурия.
Положительная сахарозная проба с собственными эритроцитами.
Слайд 36ГА с неполными тепловыми агглютининами
Клиника- м.б., внезапное начало-лихорадка, боли в
сердце, пояснице, одышка, желтуха. М.б., постепенное начало с артралгии, нарастающая
анемизация, гепато- и спленомегалия. М.б., тромбозы периферических вен, мезентериальных сосудов боли в животеАнализ крови- анемия, ретикулоцитоз, лейкоцитоз со сдвигом влево, анизоцитоз и полихромазия, СОЭ.
Биохимия- непрямой билирубин, уробилин, стеркобилин. М.б., положительная реакция Вассермана. СОЭ.
Положительная прямая проба Кумбса (неполные а/т на поверхности эритроцитов)
Слайд 37ГА с полными холодовыми агглютининами.
Клиника-начало постепенное, слабость, быстрая утомляемость, непереносимость
холода, часто синдром Рейно, при длительном воздействии холода м.б.гангрена пальцев.
Иногда гепато- и спленомегалия.Биохимия - обнаруживается М-градиент (содержит холодовые агглютинины). Часто аутоагглютинация в мазке крови и пробирке при комнатной tº.
Слайд 39Лечение ГА
Устранение причины острого гемолиза;
При кризах – ГКС-терапия;
Спленэктомия (при
аутоиммунных ГА и сфероцитозе)
Эксиджад (ликвидация вторичного гемосидероза)
Эритропоэтин ( при гемоглобинопатиях)
Переливания
крови (Î Î Î очень осторожно, т.к. ведет к гемосидерозу, только при тяжелых гемолитических кризах)Слайд 40Апластическая анемия- это функциональная недостаточность костного мозга, в результате чего
нарушается пролиферация и дифференциация клеток последнего.
Слайд 41Этиология .
Ионизирующая радиация;
Химические вещества;
Цитотоксические препараты;
Вирусные инфекции (вирусный гепатит);
Наследственные факторы (анемия
Фанкони, син-м Даймонда-Блекфана, наслед. дефицит гормонов поджелудочной железы);
Лекарственные препараты (сульфанил-амиды;
левомицетин; аминазин и др).Слайд 42Классификация
1. Наследственные (врожденные);
2. Приобретенные:
- первичные (идиопатические);
- вторичные.
Слайд 43Клиника
1.Анемический синдром -слабость, одышка, сердцебиение при физической нагрузке.
2.Геморрагический синдром
– кровотечения из носа, десен, маточные и желудочные, на глазном
дне, петехиально-пятнистый тип крово-излияний на коже.Слайд 443.С-м инфекционных осложнений –пневмонии, ангины, отиты, пиелиты, абсцессы);
4.Гематологический синдром –
характерные изменения в крови.
Слайд 46Диагностика:
ОАК – анемия разной степени выраженности;
Панцитопения (лейкопения, нейтро-пения с абсолютной
лимфопенией; тромбоцитопения);
Анизо-пойкилоцитоз;
Нормо-или-макроцитоз;
Ускоренная СОЭ.
Слайд 47Диагностика:
Миелограмма - опустошенный костный мозг, местами имеются небольшие очаги кроветворения.
Гистологически-
запустевание костного мозга – соотношение кроветворных клеток и жира 1:3-4
(при норме 1:1).Иммунные нарушения- аутоантитела к клеткам костного мозга; снижение CD 41и CD8+ лимфоцитов.